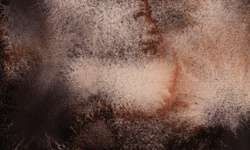
WHITE NIGHTS™ granulerende aquarelverf - los, hele nap

WHITE NIGHTS™ granulerende aquarelverf - los
Product bestellen
 Half transparant
Half transparant
 Transparant
Transparant
 half dekkend
half dekkend





 pg
Deze verf is, afhankelijk van de gebruikte pigmenten, onderverdeeld in verschillende prijsgroepen / series.
Product reviews
pg
Deze verf is, afhankelijk van de gebruikte pigmenten, onderverdeeld in verschillende prijsgroepen / series.
Product reviews
In deze keuze zijn er op het moment geen afgeprijsde artikelen. Deze keuze verwijderen: Klik hier
Kies de gewenste kleur:
Legenda
Een beoordeling schrijven
Er zijn nog geen beoordelingen voor dit product.
Ter informatie: Houd er rekening mee dat vanwege de beperkte omvang van onze winkels niet alle artikelen van de website ook in alle winkels op voorraad zijn. Om teleurstellingen te voorkomen raden wij je aan om contact op te nemen met de winkel die je wilt bezoeken, zodat we het product kunnen reserveren of bestellen.
Klanten kochten tevens deze producten